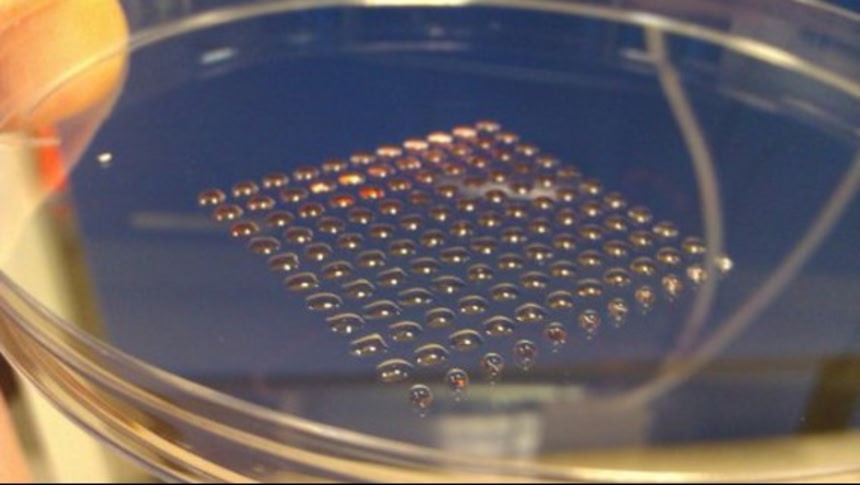

この画像を大きなサイズで見る
この画像を大きなサイズで見るイギリスとスコットランドの科学者6名で構成される研究チームは、3DプリンターでヒトES細胞(胚性幹細胞)から立体物を「印刷」することに成功したとする論文を発表した。
論文によれば、この技術が完成すれば、実験室でヒト細胞組織を作ることが可能になり、いずれは臓器提供や動物実験の必要がなくなるはずという。
これまで、インクジェット技術を用いた3Dプリンターによる印刷では、成体幹細胞などいくつかの種類の細胞の印刷に成功している。だが、成体幹細胞より万能なヒトES細胞については、3Dプリンターで使うにはもろすぎることが分かっていた。研究に参加した幹細胞関連企業ロスリン・セルラブのジェイソン・キング氏 は、今回の研究成果が長期的には動物を使わない、より信頼できる薬の安全性検査や、移植用臓器のオンデマンド提供などに計り知れない価値をもたらすと確信していると語った。
 この画像を大きなサイズで見る
この画像を大きなサイズで見る実験では、実験室で培養したヒトES細胞含む液体「バイオインク」を使い、特別に設計された「バルブ式」プリンターで印刷した。論文の共同執筆者、英ヘリオット・ワット大学のウィル・シュー氏によると、数百万の細胞を数分間で印刷できたという。
 この画像を大きなサイズで見る
この画像を大きなサイズで見る細胞は培養皿に印刷され、集まって、研究チームが「スフェロイド(回転楕円形)」と呼ぶ小さな球状のものを形成するまで放置される。1個のスフェロイドは1ミリメートル以下のサイズという。今回の実験は、特定の立体物を作製することが目標ではなく、もろいヒトES細胞に損傷を与えずに3Dプリントが可能な「手法」を実証することが目的だった。
この画像を大きなサイズで見る
この画像を大きなサイズで見るこの方法では理論上、どのような形でも印刷することが可能だが、血管網を必要とする「ヒトの臓器」はまだ再現することができない。また、ES細胞が特定の細胞組織に分化するよう導く技術の微調整も、依然として大きなハードルだ。
シュー氏は短期的な目標として、最も単純な生物学的構造を持つ臓器の1つである肝臓の組織を「3Dプリント」することを目指していると語った。
References: IO9
















細胞の人権について法整備する必要があるな
ES(iPS)細胞をコントロールできればこの技術は必要ないのでは?
過渡期の技術かな???
日本人で普通のプリンターで臓器を作ろうとした人はどうなったんだろ
この前テレビで若い東大研修医の人が患者心臓の3D映像化とそこから3Dプリンター使っての立体化をやってて驚いたなぁ
なんかこの3Dプリンター技術ってにわかにいろんな方面の先端技術に応用されてるよね
3Dプリンタで植毛とかできる時代が来るのかな
すごいけどちょっと怖い(O□O)
このまま技術が発達していけば生態部品どころか
自分のコピーまで作れるわけだ、理論上は、
まあ先の話だろうけど医療分野に応用される事を
期待しますです、ハイ(--)
3Dプリントが斜め上の方向に進歩してやがる
3Dプリンタとか高性能な機械でもマネの難しいシロモノなら
これが偶然に存在するようになることなどあろうかや
そもそも、自然でいうところの3Dプリンタや培養皿、実験室
この研究者たちは何を意味しているのであろうかや
っていう話は、今回の話題とは違うか… スマソ
3Dプリンター最近実用化進んでるな~
無機物以外も造れるなんて(・д・)
「ザ・フライ」を思い出した。
ガン化しないのかね。
どういうことだってばよ・・・
形はそっくりの機能しない臓器しか作れない
方向性が違うように思えるなあ
フィフス・エレメントの再生シーンとかに発展して行くのだろうか
レバ刺しがプリンターで作れる時代が来るな。
iPS細胞で作れるのは臓器の切れっ端だから、
いずれこの技術は必要になるよ。
「どこでもドア」が作れるぞ!
遠くに自分そっくりのコピーを作って
こっちで自分を焼き殺すってやつ!
複製生物も簡単に…